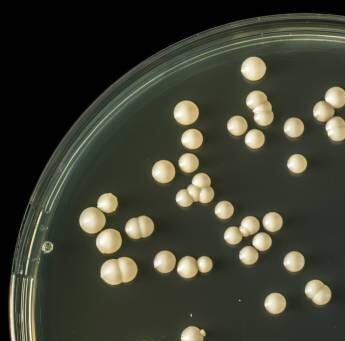

はじめに
博士課程で酵母を研究していた私にとって、酵母は「もっとも身近で扱いやすい研究材料」でした。寒天培地で育て、培養液で増やし、酵素の活性や遺伝子発現を解析する。毎日のように触れていたので、酵母を「自由自在に操れる」と錯覚していたのかもしれません。
ところが研究室を離れて家庭でパンを焼こうとすると、なぜか失敗の連続。膨らまなかったり、すっぱい匂いが残ったり、理想のふんわり食感には程遠い結果ばかりでした。同じ「酵母」を使っているはずなのに、どうしてこんなに違うのか?
今回は、そんな「研究と日常のギャップ」を通して、酵母の奥深さをご紹介します。
酵母とはどんな生き物か
酵母(Saccharomyces cerevisiae)は、単細胞の真菌(カビやキノコの仲間)です。顕微鏡で観察すると丸や楕円形の小さな細胞が並び、出芽と呼ばれる方法で増えていきます。
酵母の最大の特徴は「発酵」です。糖を分解してアルコールと二酸化炭素を生み出します。この働きによって:
•パン:二酸化炭素で生地を膨らませる
•ビール・ワイン:アルコールを生成する
•日本酒:米を糖化した後にアルコール発酵を行う
といった多彩な食品・飲料が生まれます。

この発酵のメカニズムは、納豆の驚くべき健康効果や味噌の種類と使い分けで解説している発酵食品と同様に、微生物の働きによるものです。
研究室の酵母とキッチンの酵母
研究室の酵母は、常に「整った環境」で育ちます。
培養液には必要な栄養がすべて含まれ、温度やpHも安定しており、他の微生物の混入はほぼありません。
研究者が思い描いた通りに、再現性のあるデータを出してくれる存在です。
一方、家庭のパン酵母は全く違います。
- 室温や湿度に大きく左右される
- 小麦粉や水の種類で発酵具合が変わる
- 生地のこね方や発酵時間にも敏感
研究室では「制御された安定した世界」だった酵母が、家庭では「環境に翻弄される繊細な存在」になるのです。


パン作りで失敗する理由
家庭でのパン作りでよくある失敗と、その科学的な理由を見ていきましょう。
失敗1:パンが膨らまない
原因:酵母の活性が低い、または死んでいる
•ドライイーストの保存状態が悪い(湿気や高温)
•水の温度が高すぎて酵母が死んだ(50℃以上)
•水の温度が低すぎて酵母が活動しない(20℃以下)
•塩を直接酵母に触れさせた(塩が酵母の活性を抑制)
解決策:
•ドライイーストは冷蔵保存し、開封後は早めに使い切る
•水の温度は30〜40℃に調整する
•塩と酵母は別々に加える
失敗2:すっぱい匂いがする
原因:過発酵(発酵時間が長すぎる)
酵母は糖を分解してアルコールと二酸化炭素を生成しますが、発酵が進みすぎると、乳酸菌や酢酸菌が増殖し、酸っぱい匂いを発生させます。
解決策:
•発酵時間を守る(1次発酵:1〜2時間、2次発酵:30分〜1時間)
•室温が高い場合は、発酵時間を短くする
失敗3:生地がベタベタする
原因:水分量が多すぎる、またはこね不足
小麦粉の種類や湿度によって、必要な水分量は変わります。また、こねが不足すると、グルテンが形成されず、生地がまとまりません。
解決策:
•レシピの水分量を目安に、生地の状態を見ながら調整する
•しっかりとこねて、グルテンを形成する
これらのトラブルシューティングは、糠床の作り方と管理や味噌の作り方で解説している発酵食品の管理と共通する重要なポイントです。
日常に潜む酵母
酵母といえばパンやビールを思い浮かべる人が多いですが、実はもっと身近な存在です。ブドウやリンゴの皮には自然に酵母が付着していて、昔は果物から酵母を分離して酒造りをしていました。また、環境によって特徴の違う「ワイン酵母」や「ビール酵母」など、数多くの株が存在します。
同じ「酵母」という名前でも、種類や株によって性格が違い、香りや発酵スピードも異なります。つまり、酵母は「一種類の生物」ではなく「多様なキャラクターを持つグループ」と言えるのです。
パン酵母の種類と使い分けでは、ドライイースト、生イースト、天然酵母の違いを詳しく解説しています。
酵母の種類と特徴
家庭で使える酵母には、いくつかの種類があります。
ドライイースト(乾燥酵母)
最も一般的な酵母で、スーパーで手軽に購入できます。乾燥させることで長期保存が可能になり、使いたいときに水で戻すだけで使えます。
生イースト(フレッシュイースト)
水分を含んだ状態の酵母で、発酵力が強く、風味が良いのが特徴です。ただし、保存期間が短い(冷蔵で2週間程度)ため、プロのパン職人が使うことが多いです。
天然酵母
果物や穀物に自然に付着している酵母を培養したもので、独特の風味と香りが特徴です。発酵に時間がかかりますが、深い味わいのパンが焼けます。
詳しくは、パン酵母の種類と使い分けをご覧ください。
酵母と他の発酵食品の関係
酵母は、パンだけでなく、様々な発酵食品に関わっています。
•ビール・ワイン:アルコール発酵
•日本酒:麹(こうじ)と酵母の共同作業
•味噌:味噌の作り方で解説している通り、麹と乳酸菌、酵母が協力
•糠床:糠床の微生物生態系で解説している通り、乳酸菌と酵母が共生
酵母は、単独で働くこともあれば、他の微生物と協力して働くこともある、非常に柔軟な存在なのです。
小話
研究室では、酵母株を長期保存するために冷凍保存や寒天培地にストックするのが当たり前でした。
それに対して家庭用のドライイーストは、小さな袋に入れられてスーパーで売られています。
封を切った瞬間から空気や湿度の影響を受け、生き物としての「個性」が出てくるのです。
私はこのギャップに、ある意味で「研究と日常の距離感」を感じました。
完全にコントロールできる存在だと思っていた酵母も、環境次第で大きく姿を変える。
それは「実験の延長線上にある日常の面白さ」を気づかせてくれるものでした。

パン作りのコツ
研究と日常のギャップを埋めるために、私が学んだパン作りのコツをいくつかご紹介します。
1. 温度管理を徹底する
酵母の活性は温度に大きく依存します。水の温度、室温、発酵時間をレシピ通りに守ることが成功への第一歩です。
2. 材料の計量を正確に
研究と同じように、材料の計量は正確に行いましょう。特に水分量は、パンの仕上がりに大きく影響します。
3. 生地の状態を観察する
レシピはあくまで目安です。生地の状態を観察し、必要に応じて水分量や発酵時間を調整しましょう。
4. 失敗を恐れない
失敗は学びのチャンスです。何が原因で失敗したのかを考え、次に活かしましょう。
まとめ
酵母は研究と日常をつなぐ、もっとも身近で奥深い微生物です。
実験室では思い通りに培養できても、家庭でのパン作りでは意外な難しさに出会う。
そのギャップは、科学の知識を超えて「生き物のしたたかさ」を感じさせてくれます。
パンやお酒を口にするとき、そこに「小さな酵母のはたらき」があることを思い出すと、いつもの一口が少し特別に感じられるかもしれません。
関連記事
•パン酵母の種類と使い分け:ドライイースト、生イースト、天然酵母の違い
参考文献
•日本パン技術研究所
•日本酵母工業会
•Barnett, J. A., et al. (2000). “Yeasts: Characteristics and Identification.” Cambridge University Press.
